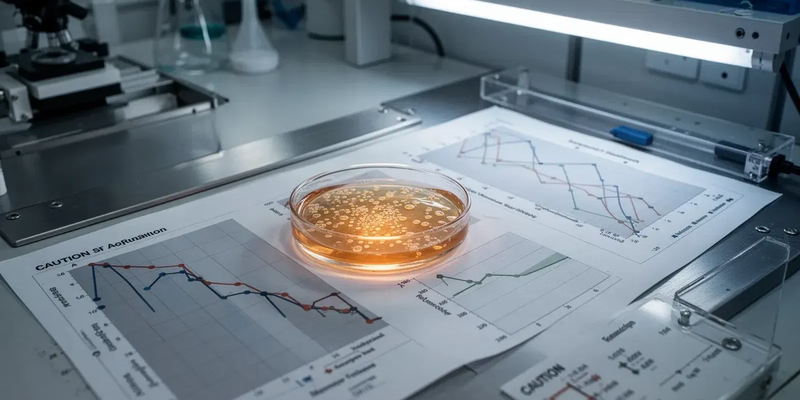
Abivax Aktie: Analysten-Dämpfer - Foto: über boerse-global.de

Abivax Aktie: Analysten-Dämpfer
25.02.2026 - 09:19:16 | boerse-global.deDie Aktie von Abivax geriet gestern unter Druck, nachdem eine negative Analysteneinschätzung die zeitgleiche Präsentation klinischer Daten überschattete. Während das Unternehmen in Stockholm Fortschritte bei seinem Hoffnungsträger Obefazimod aufzeigte, sorgte ein skeptisches Votum für Verkäufe im US-Handel. Kann die klinische Pipeline die Bewertungssorgen der Marktbeobachter langfristig entkräften?
Wedbush sieht begrenztes Potenzial
Das Analysehaus Wedbush startete gestern die Abdeckung der Aktie mit dem Rating „Underperform“. Die Analysten begründeten ihre vorsichtige Haltung vor allem mit den hohen Markterwartungen hinsichtlich einer möglichen Übernahme. Diese Spekulationen seien bereits weitgehend eingepreist, was das Chance-Risiko-Profil vor den nächsten Studienergebnissen verschlechtere. In der Folge gab das Papier im US-Handel um rund 5,4 % nach und notierte bei 125,01 USD.
Überzeugende Sicherheitsdaten in Phase 3
Parallel zur Kursbewegung veröffentlichte Abivax auf dem ECCO-Kongress in Stockholm umfassende Daten aus den Phase-3-Studien ABTECT-1 und ABTECT-2 zur Behandlung von Colitis ulcerosa. Die Analyse von 1.272 Patienten bestätigte ein günstiges Sicherheitsprofil: Schwere unerwünschte Ereignisse traten bei der 50-mg-Dosierung von Obefazimod in 3,1 % der Fälle auf – ein Wert, der auf dem Niveau der Placebo-Gruppe (3,2 %) liegt. Die am häufigsten beobachtete Nebenwirkung waren leichte, kurzzeitig auftretende Kopfschmerzen.
Zudem belegen die klinischen Auswertungen einen schnellen Wirkungseintritt. Bereits ab der ersten Behandlungswoche verzeichneten Patienten eine symptomatische Verbesserung, wobei die Remissionsraten bis zur achten Woche kontinuierlich anstiegen. Präklinische Modelle deuteten zudem auf eine signifikante Reduktion von Fibrose-Markern hin, was den geplanten Einsatz des Wirkstoffs bei Morbus Crohn unterstützt.
Sollten Anleger sofort verkaufen? Oder lohnt sich doch der Einstieg bei Abivax?
Entscheidende Meilensteine im Jahr 2026
Die aktuelle Kursentwicklung spiegelt eine Phase der Konsolidierung wider, nachdem der Titel zuvor von strategischen Gerüchten profitiert hatte. Das Management ordnete entsprechende Berichte zuletzt als Marktgeräusche ein und fokussiert sich auf die operative Umsetzung der klinischen Programme.
Für die fundamentale Bewertung der Aktie stehen im weiteren Jahresverlauf zwei Termine im Fokus: Im zweiten Quartal 2026 werden die Ergebnisse der 44-wöchigen Phase-3-Erhaltungsstudie bei Colitis ulcerosa erwartet. Im vierten Quartal folgen zudem die Top-Line-Daten der Phase-2b-Studie (ENHANCE-CD) für den Einsatz bei Morbus Crohn. Diese Ergebnisse werden darüber entscheiden, ob sich Obefazimod als differenzierte orale Therapieoption im Marktumfeld etablieren kann.
Abivax-Aktie: Kaufen oder verkaufen?! Neue Abivax-Analyse vom 25. Februar liefert die Antwort:
Die neusten Abivax-Zahlen sprechen eine klare Sprache: Dringender Handlungsbedarf für Abivax-Aktionäre. Lohnt sich ein Einstieg oder sollten Sie lieber verkaufen? In der aktuellen Gratis-Analyse vom 25. Februar erfahren Sie was jetzt zu tun ist.
Abivax: Kaufen oder verkaufen? Hier weiterlesen...
Hol dir den Wissensvorsprung der Aktien-Profis.
Seit 2005 liefert der Börsenbrief trading-notes verlässliche Trading-Empfehlungen – dreimal die Woche, direkt ins Postfach. 100% kostenlos. 100% Expertenwissen. Trage einfach deine E-Mail Adresse ein und verpasse ab heute keine Top-Chance mehr. Jetzt kostenlos anmelden
Jetzt abonnieren.